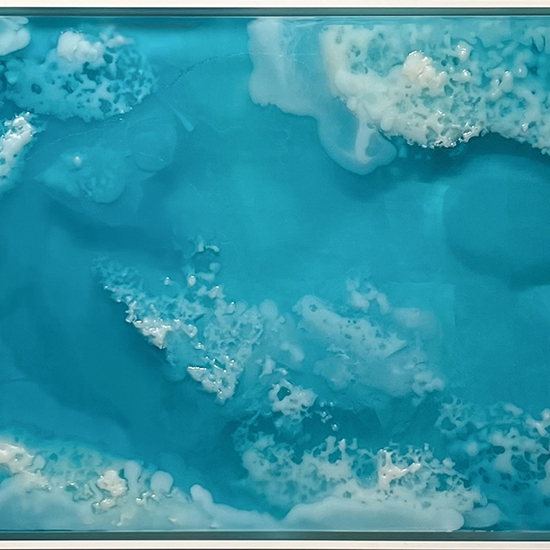
Alva Gallagher: Refuge, 2021, Cast resin, 24 x 48 inches (framed dimensions: 25.5 x 49.5 x 2 inches)

Contact GALLERY@WINSTONWACHTER.COM for more information
Winston Wächter Fine Art is pleased to participate in the Seattle Art Fair 2022. Featuring a selection of our represented artists, this work showcases a diversity of influence, concept, and technique across varied mediums and styles. Participating artists include Peter Gronquist, Matt Gagnon, Tony Scherman, Jessica Lichtenstein, Michael Schultheis, Devon Tsuno, Julie Speidel, Brian Sanchez, Marcel Rozek, Sara Genn, Alva Gallagher Andrew Casto, Chris Trueman, Tatyana Murray, and Philip Govedare.
Located at:
Lumen Field Event Center
800 Occidental Ave S
Seattle, WA 98134
Booth A05
Thursday, July 21
6:00pm — 9:00pm | Exclusive Entry for Fair Pass Holders and Select VIPs
Fair Hours:
Friday, July 22 — 12:00 to 8:00pm
Saturday, July 23 — 11:00am to 7:00pm
Sunday, July 24 — 11:00am to 6:00pm
VISIT SEATTLE ART FAIR WEBSITE HERE
[video width="350" height="195" mp4="https://seattle.winstonwachter.com/wp-content/uploads/2022/06/Gallagher_WWFA_SAF_2022_video.mp4"][/video]